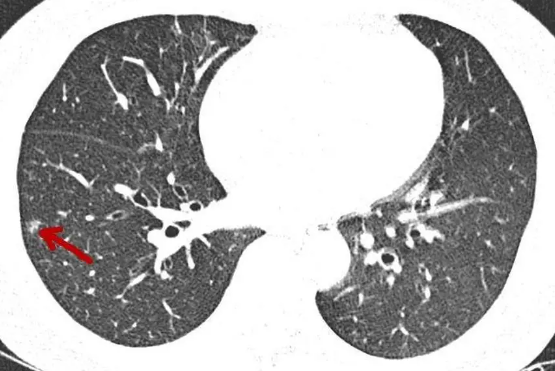
肺部结节

随着胸部CT检查的普及,越来越多的肺部结节被发现,其中一些是良性的,也有一些是早期肺癌或癌前病变。从肺部结节的各个方面总结一下,形成一篇通俗易懂又简单明了的科普文章,希望对检查发现肺部结节朋友全面准确认识对待它有一定的帮助。
1、什么是肺部结节?有哪几类?
肺内小于3厘米的占位性病灶叫结节,大于3厘米的叫肿块。肺结节包括纯磨玻璃结节、混合磨玻璃结节以及实性结节。其中以混合磨玻璃结节最可能为恶性。
2、做什么检查来发现肺部结节?PET-CT对肺部结节意义大不大?
薄层胸部CT扫描是发现肺部结节的最佳手段。胸片对肺部结节价值有限。PET-CT对实性较大结节有一定意义,对磨玻璃结节无显著价值,而且还贵!
3、哪些人应该进行CT筛查?
按指南,高危人群需筛查(长期吸烟、有肿瘤史或肿瘤家族史、有害物质接触或职业史、慢性肺疾病史等)。但临床中碰到年龄最小的才18岁也有肺癌,20几岁的多了去了,所以个人以为成年人都得查一次CT,高危的或40岁以上的每年一次,其他的可以每2年一次。
4、如何判断结节的良恶性?
这是非常专业的知识,请交给专科医生来判断。但从临床经验来看,以下几点比较有普遍性:(1)小而实的结节多数是良性;(2)持续存在的纯磨玻璃结节基本是恶性,不过恶性度低,进展缓慢;(3)磨玻璃结节中瘤肺边界清楚的多为恶性;(4)实性结节边界光整比较圆形的良性可能更大,而若边缘有细毛刺、分叶、胸膜凹陷、空泡或空腔征等则容易是恶性;(5)实性成分若收缩纠集感比较明显,则恶性可能更大;(6)多发磨玻璃结节容易是多原发癌;多发实性结节则容易是良性病变。
5、肺部结节需不需要穿刺活检?
靠中央的不容易穿,靠边上的没必要穿。穿刺还有假阴性,影像的判断在有经验的医生看来,已经比较准确。胸腔镜下微创切除病检兼有诊断与治疗作用,更值得选择。

6、随访时间如何确定?
初次发现的纯磨玻璃结节建议4-6个月复查(具体需视结节大小)以确定是否持续存在;混合磨玻璃结节与实性结节视良恶性可能性大小确定不同的随访间隔时间,恶性可能越大的随访间隔越短,比如4-6周或6-8周等。随访无变化的可以适当逐步延长间隔时间,但仍最长2年需查一次CT。随访进展均需积极干预。